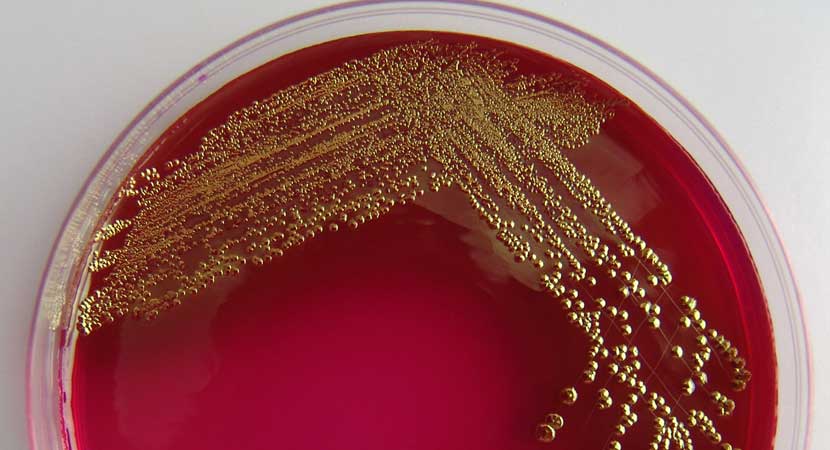
Biotechnology

- Multinational (0)
- Auto Directory & Boat Guide (5)
- Arts Entertainment (6)
- Business, Professionals & Services (6)
- Computers, Software & Electronics (5)
- Construction (2)
- Education & Training (2)
- Entertainment & Social Activities (1)
- Family & Community (0)
- Finance (1)
- Food & Beverage Industry (1)
- Gastronomy (0)
- Health & Medicine (0)
- Industry, Supplies & Equipment (0)
- Personal Care & Beauty (0)
- Science & Environment (0)
- Shopping & Specialty Stores (0)
- Sports and Recreation (0)
- Tourism & Voyage (0)
- Transportation (0)
- Wedding & Event Planning (0)
Biotechnology
×Want to always see your Listings on top, Click Here
Search Tips:
No records found that match your selection.Check for spelling mistake in the search keyword
Try using alternate term(s) for your search keywords
